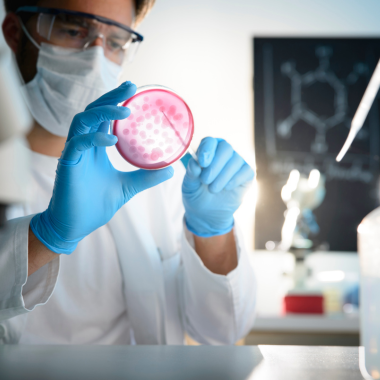

OUR DIAGNOSTICS EXPERTISE
Discover Unparalleled
Diagnostics Excellence
Where precision meets care, trust in our expertise for accurate diagnoses and comprehensive solutions.
Pathways to Precision: Your Health, Our Expertise
CLINICAL PATHOLOGY
We specialize in analyzing bodily fluids and tissues to provide accurate insights into your health. From blood counts to urinalysis, our comprehensive tests aid in early detection and monitoring of various medical conditions, ensuring proactive healthcare management.
Services Offered:
- Blood Counts and Hematology
- Urinalysis and Fluid Examination
- Coagulation Profiles
- Blood Chemistry Panels
- Tissue Biopsies and Cytology


Illuminating Health Through Biochemical Insights
BIOCHEMISTRY
Our laboratory specializes in analyzing biochemical markers to unveil crucial insights into your health status. From lipid profiles to liver function tests, our comprehensive panels aid in the early detection and monitoring of metabolic disorders, empowering proactive healthcare management.
Services Offered:
- Lipid Profiles
- Liver Function Tests
- Renal Function Panels
- Glucose and HbA1c Testing
- Electrolyte Analysis
Unraveling Viral Mysteries, Safeguarding Communities
VIROLOGY
Our laboratory is dedicated to identifying and characterizing viral pathogens with precision and efficiency. From viral cultures to molecular assays, we offer comprehensive testing solutions crucial for the early detection and management of viral infections, ensuring public health safety.
Services Offered:
- Viral Cultures
- Polymerase Chain Reaction (PCR) Testing
- Serological Assays
- Viral Load Monitoring
- Antiviral Susceptibility Testing


Elevating Healthcare Through Immunochemical Precision
IMMUNOCHEMISTRY
Our laboratory specializes in analyzing immune markers to provide invaluable insights into your health. From autoimmune panels to allergy testing, our comprehensive assays aid in early detection and management of immune-related disorders, fostering proactive healthcare strategies.
Services Offered:
- Autoimmune Panels
- Allergy Testing (IgE)
- Immune Response Profiling
- Tumor Marker Assays
- Hormone Analysis
Unveiling Parasitic Realities for Holistic Health
PARASITOLOGY
Our laboratory is committed to identifying and characterizing parasitic organisms with precision and efficiency. From stool examinations to blood smears, our comprehensive testing solutions are essential for the early detection and management of parasitic infections, ensuring optimal health outcomes.
Services Offered:
- Stool Examinations (Ova and Parasites)
- Blood Smears for Malaria and Other Blood-borne Parasites
- Serological Testing for Parasitic Infections
- Intestinal Protozoa Identification
- Parasitic Worm Identification and Analysis


Serology Solutions: Mapping Immune Landscapes
SEROLOGY
Our laboratory meticulously analyzes antibodies and antigens to unveil critical immune responses. From infectious disease serology to autoimmune markers, our comprehensive assays aid in early detection and monitoring of immune-related conditions, guiding personalized treatment strategies for optimal health outcomes.
Services Offered:
- Infectious Disease Serology
- Autoimmune Marker Detection
- Antibody Titration
- Rheumatoid Factor Testing
- Viral Antibody Panels
Histopathology: Illuminating Cellular Narratives for Healing Journeys
HISTOPATHOLOGY
Our laboratory meticulously examines tissue specimens to unravel intricate pathological insights. From cancer diagnosis to organ pathology, our comprehensive analyses aid in understanding disease processes and guiding tailored treatment strategies, fostering hope and healing for our patients.
Services Offered:
- Cancer Biopsy Examination
- Organ Pathology Assessment
- Tumor Grading and Staging
- Immunohistochemistry Staining
- Frozen Section Analysis

Microbiology Unveiled: Decoding Microbial Mysteries for Healthier Futures
MICROBIOLOGY
Our laboratory meticulously identifies bacteria, viruses, fungi, and parasites to unveil crucial insights into infectious diseases. From culture and sensitivity testing to molecular diagnostics, our comprehensive analyses aid in accurate diagnosis and targeted treatment, safeguarding health and well-being.
Services Offered:
- Bacterial Culture and Sensitivity Testing
- Viral Culture and PCR Testing
- Fungal Culture and Antifungal Susceptibility Testing
- Parasitological Examination
- Molecular Diagnostics for Infectious Diseases
Endocrinology Insights: Balancing Hormonal Harmony for Lifelong Wellness
ENDOCRINOLOGY
Our laboratory meticulously analyzes hormonal markers to unveil essential insights into metabolic and endocrine disorders. From thyroid function tests to hormone panels, our comprehensive assays aid in early detection and personalized management, ensuring optimal health and vitality.
Services Offered:
- Thyroid Function Tests
- Hormone Panels (e.g., FSH, LH, Testosterone, Estrogen)
- Adrenal Function Testing
- Diabetes-related Markers (e.g., HbA1c, C-peptide)
- Pituitary Function Assessment
